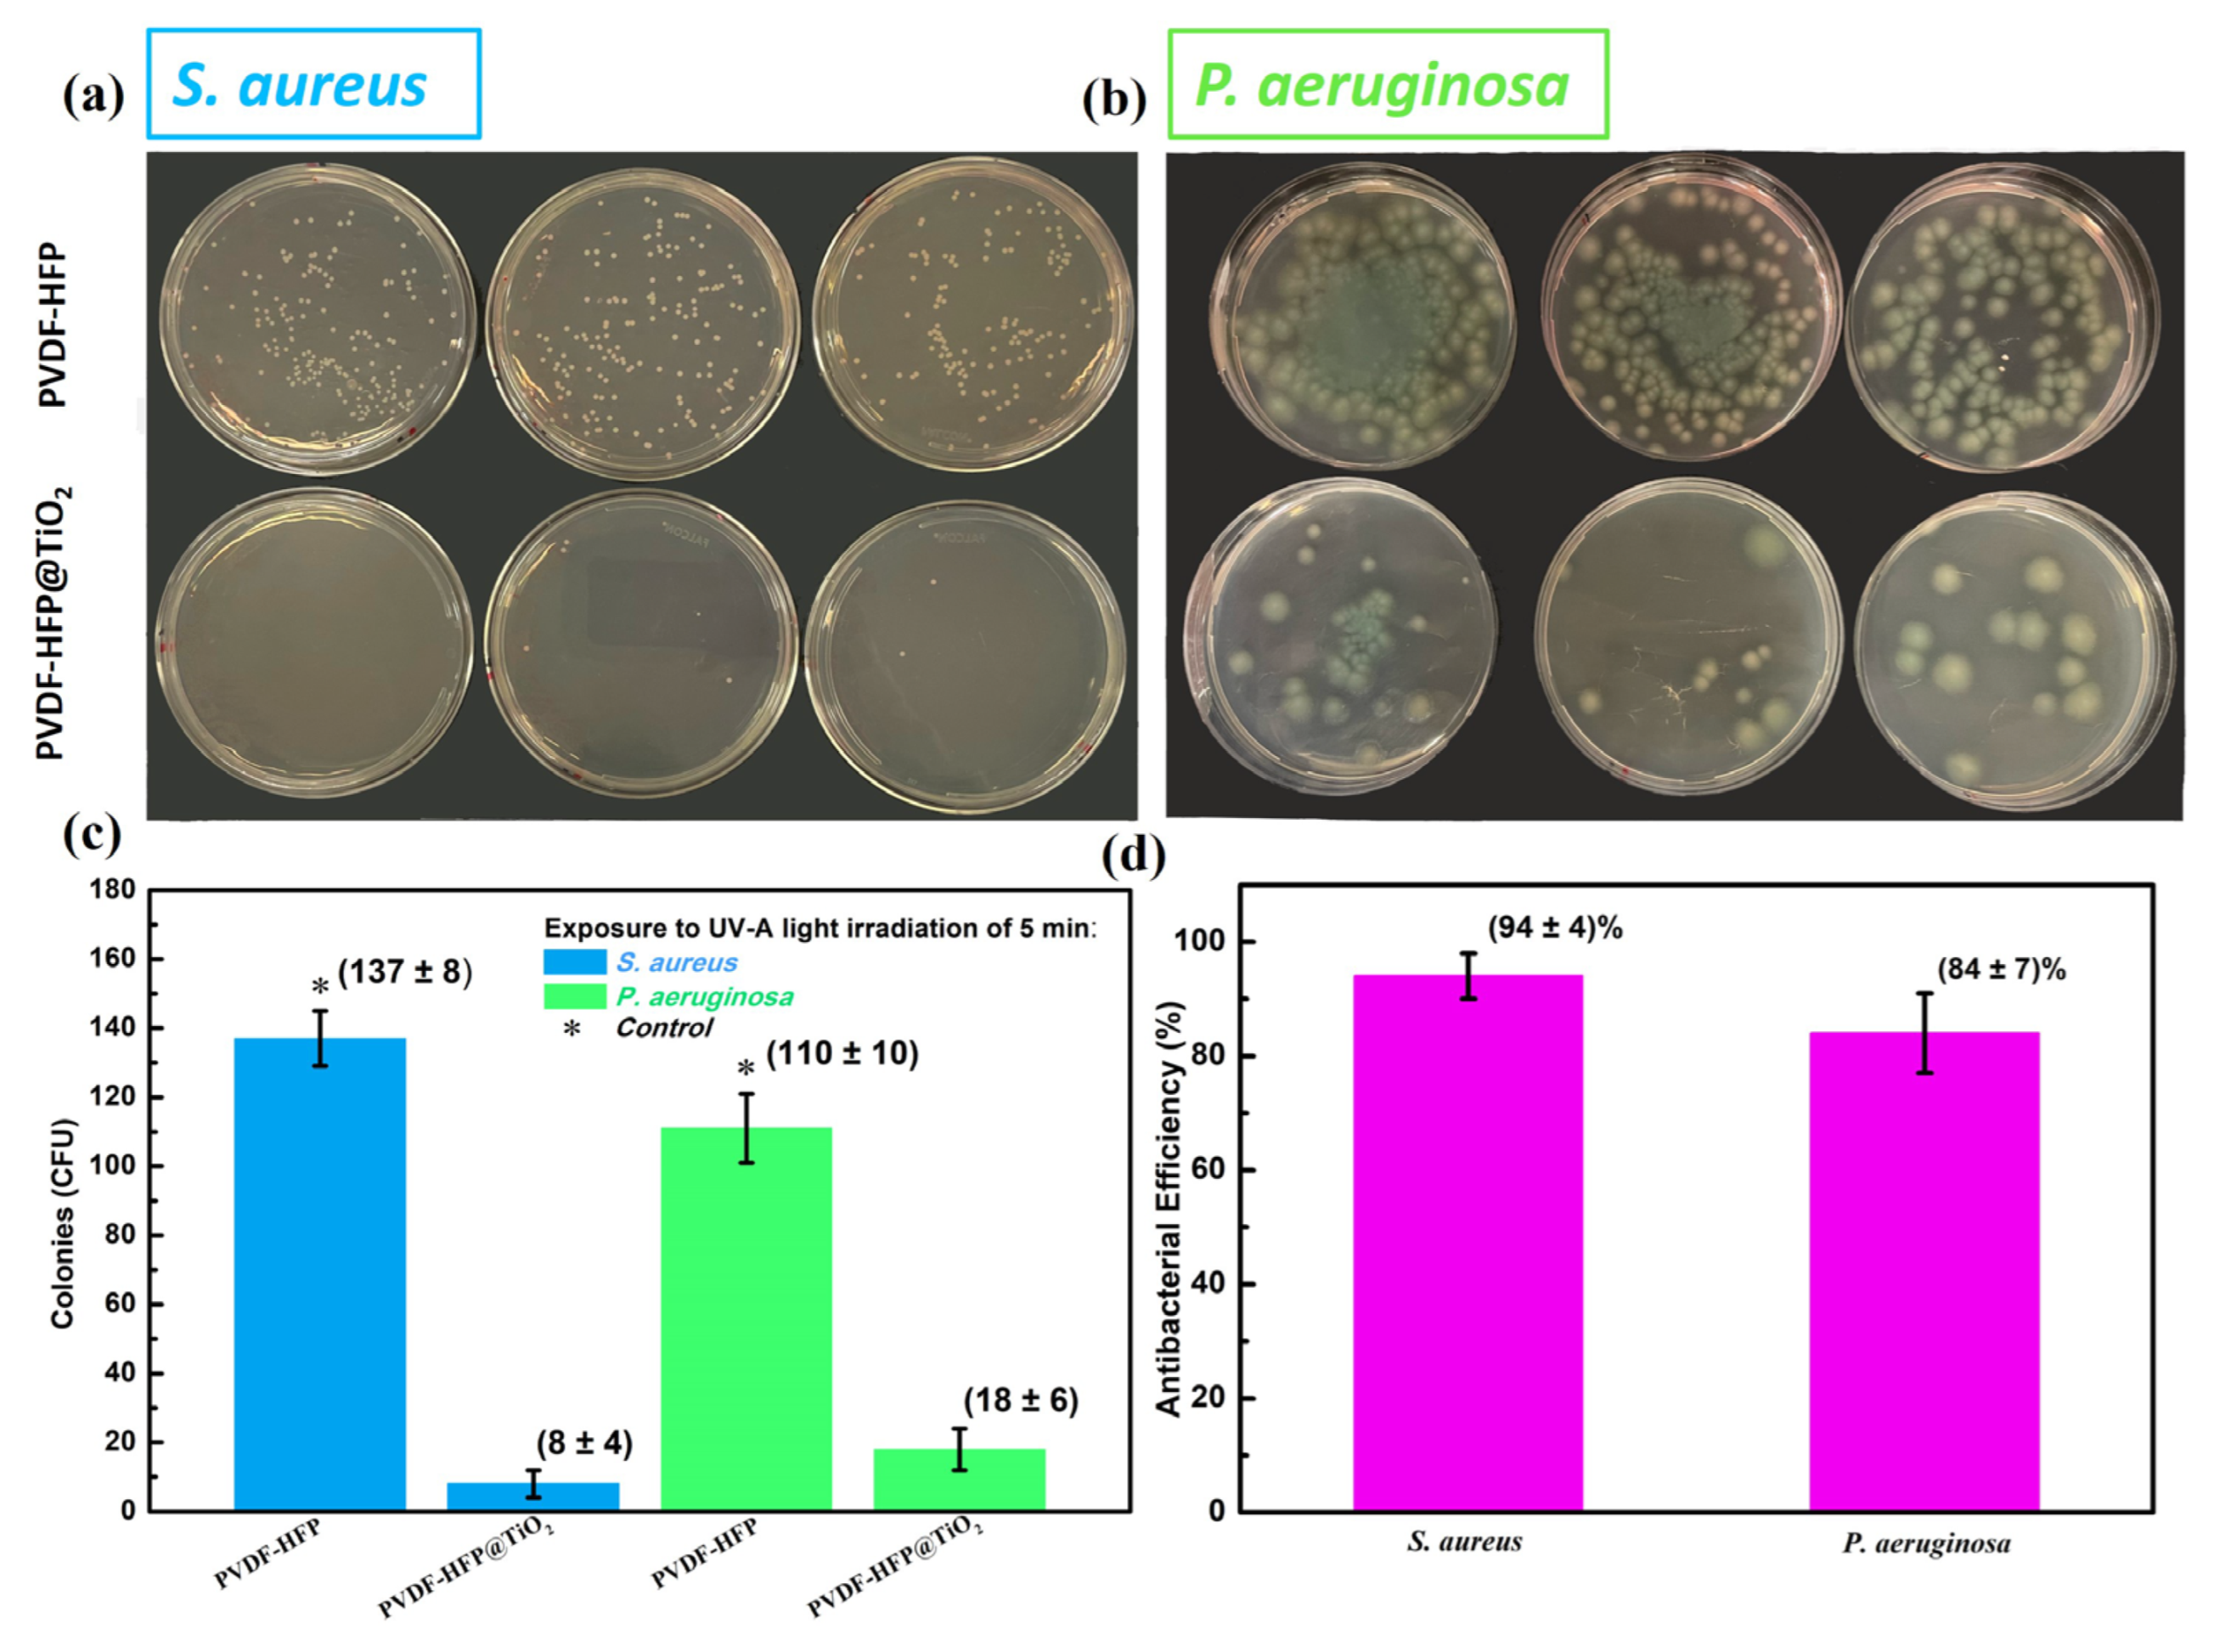
Polymers 15 04586 g003 Polymers 15 04586 g003

Upscaling of Electrospinning Technology and the Application of Functionalized PVDF-HFP@TiO2 Electrospun Nanofibers for the Rapid Photocatalytic Deactivation of Bacteria on Advanced Face Masks
Abstract
1. Introduction
2. Materials and Methods
2.1. Method for Fabrication of Nanofibers
2.2. Characterization Method
2.3. Photocatalytic and Antibacterial Experiment
2.4. Filtration and Pressure Drop Testing Methods
2.5. Mechanical Properties
2.6. Wettability Properties
3. Results and Discussion
3.1. Characterization of the Nanofibrous Membranes
3.2. Antibacterial Test
3.3. Filtration Performance
4. Conclusions
Supplementary Materials
Author Contributions
Funding
Institutional Review Board Statement
Data Availability Statement
Acknowledgments
Conflicts of Interest
References
- Ippolito, M.; Vitale, F.; Accurso, G.; Iozzo, P.; Gregoretti, C.; Giarratano, A.; Cortegiani, A. Medical Masks and Respirators for the Protection of Healthcare Workers from SARS-CoV-2 and Other Viruses. Pulmonology 2020, 26, 204–212. [Google Scholar] [CrossRef] [PubMed]
- Bandiera, L.; Pavar, G.; Pisetta, G.; Otomo, S.; Mangano, E.; Seckl, J.R.; Digard, P.; Molinari, E.; Menolascina, F.; Viola, I.M. Face Coverings and Respiratory Tract Droplet Dispersion. R. Soc. Open Sci. 2020, 7, 201663. [Google Scholar] [CrossRef]
- Bałazy, A.; Toivola, M.; Adhikari, A.; Sivasubramani, S.K.; Reponen, T.; Grinshpun, S.A. Do N95 Respirators Provide 95% Protection Level against Airborne Viruses, and How Adequate Are Surgical Masks? Am. J. Infect. Control 2006, 34, 51–57. [Google Scholar] [CrossRef]
- O’Dowd, K.; Nair, K.M.; Forouzandeh, P.; Mathew, S.; Grant, J.; Moran, R.; Bartlett, J.; Bird, J.; Pillai, S.C. Face Masks and Respirators in the Fight Against the COVID-19 Pandemic: A Review of Current Materials, Advances and Future Perspectives. Materials 2020, 13, 3363. [Google Scholar] [CrossRef] [PubMed]
- Islam, M.S.; Larpruenrudee, P.; Saha, S.C.; Pourmehran, O.; Paul, A.R.; Gemci, T.; Collins, R.; Paul, G.; Gu, Y. How Severe Acute Respiratory Syndrome Coronavirus-2 Aerosol Propagates through the Age-Specific Upper Airways. Phys. Fluids 2021, 33, 081911. [Google Scholar] [CrossRef]
- Prather, K.A.; Wang, C.C.; Schooley, R.T. Reducing Transmission of SARS-CoV-2. Science 2020, 368, 1422–1424. [Google Scholar] [CrossRef]
- Ju, J.T.J.; Boisvert, L.N.; Zuo, Y.Y. Face Masks against COVID-19: Standards, Efficacy, Testing and Decontamination Methods. Adv. Colloid Interface Sci. 2021, 292, 102435. [Google Scholar] [CrossRef]
- Cimini, A.; Imperi, E.; Picano, A.; Rossi, M. Electrospun Nanofibers for Medical Face Mask with Protection Capabilities against Viruses: State of the Art and Perspective for Industrial Scale-Up. Appl. Mater. Today 2023, 32, 101833. [Google Scholar] [CrossRef]
- EN 14683+AC; Medical Face Masks: Requirements and Test Methods. European Standards: Pilsen, Czech Republic, 2019. Available online: https://www.en-standard.eu/csn-en-14683-ac-medical-face-masks-requirements-and-test-methods/ (accessed on 1 November 2023).
- EN149:2001+A1:2009; Respiratory Protective Devices. Filtering Half Masks to Protect Against Particles. Requirements, Testing, Marking. European Standards: Pilsen, Czech Republic, 2009. Available online: https://www.en-standard.eu/bs-en-149-2001-a1-2009-respiratory-protective-devices-filtering-half-masks-to-protect-against-particles-requirements-testing-marking/ (accessed on 1 November 2023).
- Whiley, H.; Keerthirathne, T.P.; Nisar, M.A.; White, M.A.F.; Ross, K.E. Viral Filtration Efficiency of Fabric Masks Compared with Surgical and N95 Masks. Pathogens 2020, 9, 762. [Google Scholar] [CrossRef]
- Landry, S.A.; Subedi, D.; Barr, J.J.; MacDonald, M.I.; Dix, S.; Kutey, D.M.; Mansfield, D.; Hamilton, G.S.; Edwards, B.A.; Joosten, S.A. Fit-Tested N95 Masks Combined with Portable High-Efficiency Particulate Air Filtration Can Protect Against High Aerosolized Viral Loads Over Prolonged Periods at Close Range. J. Infect. Dis. 2022, 226, 199–207. [Google Scholar] [CrossRef] [PubMed]
- Filipić, A.; Fric, K.; Ravnikar, M.; Kogovšek, P. Assessment of Different Experimental Setups to Determine Viral Filtration Efficiency of Face Masks. Int. J. Environ. Res. Public Health 2022, 19, 15353. [Google Scholar] [CrossRef]
- Armentano, I.; Barbanera, M.; Carota, E.; Crognale, S.; Marconi, M.; Rossi, S.; Rubino, G.; Scungio, M.; Taborri, J.; Calabrò, G. Polymer Materials for Respiratory Protection: Processing, End Use, and Testing Methods. ACS Appl. Polym. Mater. 2021, 3, 531–548. [Google Scholar] [CrossRef]
- Guan, X.; Lin, J.; Han, J.; Gao, X.; Zhang, Y.; Hu, B.; Guidoin, R.; Wang, L. Prolonged Use of Surgical Masks and Respirators Affects the Protection and Comfort for Healthcare Workers. Materials 2022, 15, 7918. [Google Scholar] [CrossRef] [PubMed]
- Scarano, A.; Inchingolo, F.; Lorusso, F. Facial Skin Temperature and Discomfort When Wearing Protective Face Masks: Thermal Infrared Imaging Evaluation and Hands Moving the Mask. Int. J. Environ. Res. Public Health 2020, 17, 4624. [Google Scholar] [CrossRef] [PubMed]
- Liao, M.; Liu, H.; Wang, X.; Hu, X.; Huang, Y.; Liu, X.; Brenan, K.; Mecha, J.; Nirmalan, M.; Lu, J.R. A Technical Review of Face Mask Wearing in Preventing Respiratory COVID-19 Transmission. Curr. Opin. Colloid Interface Sci. 2021, 52, 101417. [Google Scholar] [CrossRef]
- Buzzin, A.; Domènech-Gil, G.; Fraschetti, E.; Giovine, E.; Puglisi, D.; Caputo, D. Assessing the Consequences of Prolonged Usage of Disposable Face Masks. Sci. Rep. 2022, 12, 16796. [Google Scholar] [CrossRef]
- Armand, Q.; Whyte, H.E.; Verhoeven, P.; Grattard, F.; Leclerc, L.; Curt, N.; Ragey, S.P.; Pourchez, J. Impact of Medical Face Mask Wear on Bacterial Filtration Efficiency and Breathability. Environ. Technol. Innov. 2022, 28, 102897. [Google Scholar] [CrossRef]
- Essa, W.; Yasin, S.; Saeed, I.; Ali, G. Nanofiber-Based Face Masks and Respirators as COVID-19 Protection: A Review. Membranes 2021, 11, 250. [Google Scholar] [CrossRef]
- Salam, A.; Hassan, T.; Jabri, T.; Riaz, S.; Khan, A.; Iqbal, K.M.; Khan, S.U.; Wasim, M.; Shah, M.R.; Khan, M.Q.; et al. Electrospun Nanofiber-Based Viroblock/ZnO/PAN Hybrid Antiviral Nanocomposite for Personal Protective Applications. Nanomaterials 2021, 11, 2208. [Google Scholar] [CrossRef]
- Li, Q.; Yin, Y.; Cao, D.; Wang, Y.; Luan, P.; Sun, X.; Liang, W.; Zhu, H. Photocatalytic Rejuvenation Enabled Self-Sanitizing, Reusable, and Biodegradable Masks against COVID-19. ACS Nano 2021, 15, 11992–12005. [Google Scholar] [CrossRef]
- Chen, P.; Yang, Z.; Mai, Z.; Huang, Z.; Bian, Y.; Wu, S.; Dong, X.; Fu, X.; Ko, F.; Zhang, S.; et al. Electrospun Nanofibrous Membrane with Antibacterial and Antiviral Properties Decorated with Myoporum Bontioides Extract and Silver-Doped Carbon Nitride Nanoparticles for Medical Masks Application. Sep. Purif. Technol. 2022, 298, 121565. [Google Scholar] [CrossRef]
- Li, M.; Wen, H.; Li, H.; Yan, Z.-C.; Li, Y.; Wang, L.; Wang, D.; Tang, B.Z. AIEgen-Loaded Nanofibrous Membrane as Photodynamic/Photothermal Antimicrobial Surface for Sunlight-Triggered Bioprotection. Biomaterials 2021, 276, 121007. [Google Scholar] [CrossRef]
- Lim, Q.F.; Yap, R.C.C.; Teng, C.P.; Yeo, J.C.C.; Tan, M.Y.; Toh, J.P.W.; Zhu, Q.; Thitsartarn, W.; He, C.; Liu, S.; et al. Electrospray-on-Electrospun Breathable, Biodegradable, and Robust Nanofibrous Membranes with Photocatalytic Bactericidal Activity. ACS Appl. Nano Mater. 2023, 6, 1828–1838. [Google Scholar] [CrossRef]
- Shen, H.; Zhou, Z.; Wang, H.; Chen, J.; Zhang, M.; Han, M.; Shen, Y.; Shuai, D. Photosensitized Electrospun Nanofibrous Filters for Capturing and Killing Airborne Coronaviruses under Visible Light Irradiation. Environ. Sci. Technol. 2022, 56, 4295–4304. [Google Scholar] [CrossRef]
- Beyth, N.; Houri-Haddad, Y.; Domb, A.; Khan, W.; Hazan, R. Alternative Antimicrobial Approach: Nano-Antimicrobial Materials. Evid.-Based Complement. Altern. Med. 2015, 2015, 246012. [Google Scholar] [CrossRef]
- Mohite, V.S.; Darade, M.M.; Sharma, R.K.; Pawar, S.H. Nanoparticle Engineered Photocatalytic Paints: A Roadmap to Self-Sterilizing against the Spread of Communicable Diseases. Catalysts 2022, 12, 326. [Google Scholar] [CrossRef]
- Liao, C.; Li, Y.; Tjong, S.C. Visible-Light Active Titanium Dioxide Nanomaterials with Bactericidal Properties. Nanomaterials 2020, 10, 124. [Google Scholar] [CrossRef] [PubMed]
- SalehHudin, H.S.; Mohamad, E.N.; Mahadi, W.N.L.; Muhammad Afifi, A. Multiple-Jet Electrospinning Methods for Nanofiber Processing: A Review. Mater. Manuf. Process. 2018, 33, 479–498. [Google Scholar] [CrossRef]
- Beaudoin, É.J.; Kubaski, M.M.; Samara, M.; Zednik, R.J.; Demarquette, N.R. Scaled-Up Multi-Needle Electrospinning Process Using Parallel Plate Auxiliary Electrodes. Nanomaterials 2022, 12, 1356. [Google Scholar] [CrossRef] [PubMed]
- Xu, Y.; Li, X.; Xiang, H.-F.; Zhang, Q.-Q.; Wang, X.-X.; Yu, M.; Hao, L.-Y.; Long, Y.-Z. Large-Scale Preparation of Polymer Nanofibers for Air Filtration by a New Multineedle Electrospinning Device. J. Nanomater. 2020, 2020, 4965438. [Google Scholar] [CrossRef]
- Kim, I.G.; Lee, J.-H.; Unnithan, A.R.; Park, C.-H.; Kim, C.S. A Comprehensive Electric Field Analysis of Cylinder-Type Multi-Nozzle Electrospinning System for Mass Production of Nanofibers. J. Ind. Eng. Chem. 2015, 31, 251–256. [Google Scholar] [CrossRef]
- Lee, C.-G.; Javed, H.; Zhang, D.; Kim, J.-H.; Westerhoff, P.; Li, Q.; Alvarez, P.J.J. Porous Electrospun Fibers Embedding TiO2 for Adsorption and Photocatalytic Degradation of Water Pollutants. Environ. Sci. Technol. 2018, 52, 4285–4293. [Google Scholar] [CrossRef] [PubMed]
- Ziental, D.; Czarczynska-Goslinska, B.; Mlynarczyk, D.T.; Glowacka-Sobotta, A.; Stanisz, B.; Goslinski, T.; Sobotta, L. Titanium Dioxide Nanoparticles: Prospects and Applications in Medicine. Nanomaterials 2020, 10, 387. [Google Scholar] [CrossRef] [PubMed]
- Zhou, T.-T.; Zhao, F.-H.; Cui, Y.-Q.; Chen, L.-X.; Yan, J.-S.; Wang, X.-X.; Long, Y.-Z. Flexible TiO2/PVDF/g-C3N4 Nanocomposite with Excellent Light Photocatalytic Performance. Polymers 2019, 12, 55. [Google Scholar] [CrossRef] [PubMed]
- Sasikumar, M.; Subiramaniyam, N.P. Microstructure, Electrical and Humidity Sensing Properties of TiO2/Polyaniline Nanocomposite Films Prepared by Sol–Gel Spin Coating Technique. J. Mater. Sci. Mater. Electron. 2018, 29, 7099–7106. [Google Scholar] [CrossRef]
- Chen, K.-N.; Sari, F.N.I.; Ting, J.-M. Multifunctional TiO2/Polyacrylonitrile Nanofibers for High Efficiency PM2.5 Capture, UV Filter, and Anti-Bacteria Activity. Appl. Surf. Sci. 2019, 493, 157–164. [Google Scholar] [CrossRef]
- Blanco, M.; Monteserín, C.; Angulo, A.; Pérez-Márquez, A.; Maudes, J.; Murillo, N.; Aranzabe, E.; Ruiz-Rubio, L.; Vilas, J.L. TiO2-Doped Electrospun Nanofibrous Membrane for Photocatalytic Water Treatment. Polymers 2019, 11, 747. [Google Scholar] [CrossRef] [PubMed]
- Kwon, M.; Kim, J.; Kim, J. Photocatalytic Activity and Filtration Performance of Hybrid TiO2-Cellulose Acetate Nanofibers for Air Filter Applications. Polymers 2021, 13, 1331. [Google Scholar] [CrossRef] [PubMed]
- Sanyal, A.; Sinha-Ray, S. Ultrafine PVDF Nanofibers for Filtration of Air-Borne Particulate Matters: A Comprehensive Review. Polymers 2021, 13, 1864. [Google Scholar] [CrossRef]
- Kianfar, P.; Bongiovanni, R.; Ameduri, B.; Vitale, A. Electrospinning of Fluorinated Polymers: Current State of the Art on Processes and Applications. Polym. Rev. 2023, 63, 127–199. [Google Scholar] [CrossRef]
- Varun, S.; George, N.M.; Chandran, A.M.; Varghese, L.A.; Mural, P.K.S. Multifaceted PVDF Nanofibers in Energy, Water and Sensors: A Contemporary Review (2018 to 2022) and Future Perspective. J. Fluor. Chem. 2023, 265, 110064. [Google Scholar] [CrossRef]
- Nunes-Pereira, J.; Ribeiro, S.; Ribeiro, C.; Gombek, C.J.; Gama, F.M.; Gomes, A.C.; Patterson, D.A.; Lanceros-Méndez, S. Poly(Vinylidene Fluoride) and Copolymers as Porous Membranes for Tissue Engineering Applications. Polym. Test. 2015, 44, 234–241. [Google Scholar] [CrossRef]
- Motamedi, A.S.; Mirzadeh, H.; Hajiesmaeilbaigi, F.; Bagheri-Khoulenjani, S.; Shokrgozar, M.A. Piezoelectric Electrospun Nanocomposite Comprising Au NPs/PVDF for Nerve Tissue Engineering. J. Biomed. Mater. Res. 2017, 105, 1984–1993. [Google Scholar] [CrossRef] [PubMed]
- Hermenegildo, B.; Meira, R.M.; Díez, A.G.; Correia, D.M.; Ribeiro, S.; Serra, J.P.; Ribeiro, C.; Pérez-Álvarez, L.; Vilas-Vilela, J.L.; Lanceros-Méndez, S. Ionic Liquid Modified Electroactive Polymer-Based Microenvironments for Tissue Engineering. Polymer 2022, 246, 124731. [Google Scholar] [CrossRef]
- Ahmed, F.; Choudhury, N.R.; Dutta, N.K.; Zannettino, A.; Knott, R. Near Superhydrophobic Fibrous Scaffold for Endothelialization: Fabrication, Characterization and Cellular Activities. Biomacromolecules 2013, 14, 3850–3860. [Google Scholar] [CrossRef]
- Ahmed, F.; Dutta, N.K.; Zannettino, A.; Vandyke, K.; Choudhury, N.R. Engineering Interaction between Bone Marrow Derived Endothelial Cells and Electrospun Surfaces for Artificial Vascular Graft Applications. Biomacromolecules 2014, 15, 1276–1287. [Google Scholar] [CrossRef] [PubMed]
- Sengupta, P.; Ghosh, A.; Bose, N.; Mukherjee, S.; Roy Chowdhury, A.; Datta, P. A Comparative Assessment of Poly(Vinylidene Fluoride)/Conducting Polymer Electrospun Nanofiber Membranes for Biomedical Applications. J. Appl. Polym. Sci. 2020, 137, 49115. [Google Scholar] [CrossRef]
- Wang, Y.; Cao, R.; Wang, C.; Song, X.; Wang, R.; Liu, J.; Zhang, M.; Huang, J.; You, T.; Zhang, Y.; et al. In Situ Embedding Hydrogen-Bonded Organic Frameworks Nanocrystals in Electrospinning Nanofibers for Ultrastable Broad-Spectrum Antibacterial Activity. Adv. Funct. Mater. 2023, 33, 2214388. [Google Scholar] [CrossRef]
- Fu, Y.; Huang, S.; Feng, Z.; Huang, L.; Zhang, X.; Lin, H.; Mo, A. MXene-Functionalized Ferroelectric Nanocomposite Membranes with Modulating Surface Potential Enhance Bone Regeneration. ACS Biomater. Sci. Eng. 2023, 9, 900–917. [Google Scholar] [CrossRef] [PubMed]
- Tuon, F.F.; Suss, P.H.; Telles, J.P.; Dantas, L.R.; Borges, N.H.; Ribeiro, V.S.T. Antimicrobial Treatment of Staphylococcus Aureus Biofilms. Antibiotics 2023, 12, 87. [Google Scholar] [CrossRef]
- Cook, M.A.; Wright, G.D. The Past, Present, and Future of Antibiotics. Sci. Transl. Med. 2022, 14, eabo7793. [Google Scholar] [CrossRef]
- Jurado-Martín, I.; Sainz-Mejías, M.; McClean, S. Pseudomonas Aeruginosa: An Audacious Pathogen with an Adaptable Arsenal of Virulence Factors. Int. J. Mol. Sci. 2021, 22, 3128. [Google Scholar] [CrossRef] [PubMed]
- He, Z.; Rault, F.; Lewandowski, M.; Mohsenzadeh, E.; Salaün, F. Electrospun PVDF Nanofibers for Piezoelectric Applications: A Review of the Influence of Electrospinning Parameters on the β Phase and Crystallinity Enhancement. Polymers 2021, 13, 174. [Google Scholar] [CrossRef]
- Filip, P.; Zelenkova, J.; Peer, P. Electrospinning of a Copolymer PVDF-Co-HFP Solved in DMF/Acetone: Explicit Relations among Viscosity, Polymer Concentration, DMF/Acetone Ratio and Mean Nanofiber Diameter. Polymers 2021, 13, 3418. [Google Scholar] [CrossRef] [PubMed]
- Ghafari, E.; Jiang, X.; Lu, N. Surface Morphology and Beta-Phase Formation of Single Polyvinylidene Fluoride (PVDF) Composite Nanofibers. Adv. Compos. Hybrid. Mater. 2018, 1, 332–340. [Google Scholar] [CrossRef]
- Cozza, E.S.; Monticelli, O.; Marsano, E.; Cebe, P. On the Electrospinning of PVDF: Influence of the Experimental Conditions on the Nanofiber Properties: Electrospinning of Poly(Vinylidene Fluoride). Polym. Int. 2013, 62, 41–48. [Google Scholar] [CrossRef]
- Sun, F.; Ren, H.-T.; Huang, S.-Y.; Li, T.-T.; Peng, H.-K.; Lin, Q.; Lou, C.-W.; Lin, J.-H. Polyvinylidene Fluoride Electrospun Fibers Loaded TiO2 for Photocatalytic Degradation and Oil/Water Separation. Fibers Polym. 2020, 21, 1475–1487. [Google Scholar] [CrossRef]
- Liu, K.; Deng, L.; Zhang, T.; Shen, K.; Wang, X. Facile Fabrication of Environmentally Friendly, Waterproof, and Breathable Nanofibrous Membranes with High UV-Resistant Performance by One-Step Electrospinning. Ind. Eng. Chem. Res. 2020, 59, 4447–4458. [Google Scholar] [CrossRef]
- Lou, L.; Wang, J.; Lee, Y.J.; Ramkumar, S.S. Visible Light Photocatalytic Functional TiO2/PVDF Nanofibers for Dye Pollutant Degradation. Part. Part. Syst. Charact. 2019, 36, 1900091. [Google Scholar] [CrossRef]
- Pais, V.; Navarro, M.; Guise, C.; Martins, R.; Fangueiro, R. Hydrophobic Performance of Electrospun Fibers Functionalized with TiO2 Nanoparticles. Text. Res. J. 2022, 92, 2719–2730. [Google Scholar] [CrossRef]
- Vinoth, S.; Kanimozhi, G.; Hari Prasad, K.; Harish, K.; Srinadhu, E.S.; Satyanarayana, N. Enhanced Ionic Conductivity of Electrospun Nanocomposite (PVDF-HFP + TiO2 Nanofibers Fillers) Polymer Fibrous Membrane Electrolyte for DSSC Application. Polym. Compos. 2019, 40, 1585–1594. [Google Scholar] [CrossRef]
- Zhu, Z.; Zhang, Y.; Shang, Y.; Wen, Y. Electrospun Nanofibers Containing TiO2 for the Photocatalytic Degradation of Ethylene and Delaying Postharvest Ripening of Bananas. Food Bioprocess. Technol. 2019, 12, 281–287. [Google Scholar] [CrossRef]
- Nasikhudin; Ismaya, E.P.; Diantoro, M.; Kusumaatmaja, A.; Triyana, K. Preparation of PVA/TiO2 Composites Nanofibers by Using Electrospinning Method for Photocatalytic Degradation. IOP Conf. Ser. Mater. Sci. Eng. 2017, 202, 012011. [Google Scholar] [CrossRef]
- Kudlek, E.; Silvestri, D.; Wacławek, S.; Padil, V.V.T.; Stuchlík, M.; Voleský, L.; Kejzlar, P.; Černík, M. TiO2 Immobilised on Biopolymer Nanofibers for the Removal of Bisphenol A and Diclofenac from Water. Ecol. Chem. Eng. S 2017, 24, 417–429. [Google Scholar] [CrossRef][Green Version]
- Choi, H.C.; Jung, Y.M.; Kim, S.B. Size Effects in the Raman Spectra of TiO2 Nanoparticles. Vib. Spectrosc. 2005, 37, 33–38. [Google Scholar] [CrossRef]
- Kernazhitsky, L.; Shymanovska, V.; Gavrilko, T.; Naumov, V.; Fedorenko, L.; Kshnyakin, V.; Baran, J. Laser-Excited Excitonic Luminescence of Nanocrystalline TiO2 Powder. Ukr. J. Phys. 2014, 59, 246–253. [Google Scholar] [CrossRef]
- Cui, W.-W.; Tang, D.-Y.; Lu, Y.-S.; Zhang, N.; Liu, L.-Z.; Mu, J.-L. Shape Stability Enhancement of PVDF Electrospun Polymer Electrolyte Membranes Blended with Poly(2-Acrylamido-2-Methylpropanesulfonic Acid Lithium). Iran. Polym. J. 2017, 26, 179–191. [Google Scholar] [CrossRef]
- Ma, J.; Zhang, Q.; Lin, K.; Zhou, L.; Ni, Z. Piezoelectric and Optoelectronic Properties of Electrospinning Hybrid PVDF and ZnO Nanofibers. Mater. Res. Express 2018, 5, 035057. [Google Scholar] [CrossRef]
- Nikolic, P.; Mudgil, P. The Cell Wall, Cell Membrane and Virulence Factors of Staphylococcus Aureus and Their Role in Antibiotic Resistance. Microorganisms 2023, 11, 259. [Google Scholar] [CrossRef]
- Wood, S.J.; Kuzel, T.M.; Shafikhani, S.H. Pseudomonas Aeruginosa: Infections, Animal Modeling, and Therapeutics. Cells 2023, 12, 199. [Google Scholar] [CrossRef]
- Hitkova, H.; Stoyanova, A.; Ivanova, N.; Sredkova, M.; Popova, V.; Iordanova, R.; Bachvarova-Nedelcheva, A. Study of antibacterial activity of nonhydrolytic synthesized TIO2 against E. coli, P. aeruginosa and S. aureus. J. Optoelectron. Biomed. Mater. 2012, 4, 9–17. [Google Scholar]
- Barnes, R.J.; Molina, R.; Xu, J.; Dobson, P.J.; Thompson, I.P. Comparison of TiO2 and ZnO Nanoparticles for Photocatalytic Degradation of Methylene Blue and the Correlated Inactivation of Gram-Positive and Gram-Negative Bacteria. J. Nanopart Res. 2013, 15, 1432. [Google Scholar] [CrossRef]
- Pan, F.; Altenried, S.; Zuber, F.; Wagner, R.S.; Su, Y.-H.; Rottmar, M.; Maniura-Weber, K.; Ren, Q. Photo-Activated Titanium Surface Confers Time Dependent Bactericidal Activity towards Gram Positive and Negative Bacteria. Colloids Surf. B Biointerfaces 2021, 206, 111940. [Google Scholar] [CrossRef] [PubMed]
- Nakano, R.; Hara, M.; Ishiguro, H.; Yao, Y.; Ochiai, T.; Nakata, K.; Murakami, T.; Kajioka, J.; Sunada, K.; Hashimoto, K.; et al. Broad Spectrum Microbicidal Activity of Photocatalysis by TiO2. Catalysts 2013, 3, 310–323. [Google Scholar] [CrossRef]
- Padovani, G.S.; Sanches, A.O.; Moura Aouada, M.R.; Malmonge, L.F.; De Paula, F.R. Photocatalytic and Antimicrobial Efficacy of PVDF/TiO2 Membranes Fabricated by Solution Blow Spinning. J. Appl. Polym. Sci. 2023, e54761. [Google Scholar] [CrossRef]
- Rivas-Moreno, F.K.; Luna-Flores, A.; Cruz-González, D.; González-Coronel, V.J.; Sánchez-Cantú, M.; Rodríguez-López, J.L.; Caudillo-Flores, U.; Tepale, N. Effect of Pluronic P103 Concentration on the Simple Synthesis of Ag and Au Nanoparticles and Their Application in Anatase-TiO2 Decoration for Its Use in Photocatalysis. Molecules 2021, 27, 127. [Google Scholar] [CrossRef] [PubMed]
- Zhang, Y.; Park, M.; Kim, H.-Y.; El-Newehy, M.; Rhee, K.Y.; Park, S.-J. Effect of TiO2 on Photocatalytic Activity of Polyvinylpyrrolidone Fabricated via Electrospinning. Compos. Part. B Eng. 2015, 80, 355–360. [Google Scholar] [CrossRef]
- Zhang, T.; Oyama, T.; Aoshima, A.; Hidaka, H.; Zhao, J.; Serpone, N. Photooxidative N-Demethylation of Methylene Blue in Aqueous TiO2 Dispersions under UV Irradiation. J. Photochem. Photobiol. A Chem. 2001, 140, 163–172. [Google Scholar] [CrossRef]
- Kazemi, F.; Mohamadnia, Z.; Kaboudin, B.; Karimi, Z. Photodegradation of Methylene Blue with a Titanium Dioxide/Polyacrylamide Photocatalyst under Sunlight. J. Appl. Polym. Sci. 2016, 133, 43386. [Google Scholar] [CrossRef]
- Lou, L.; Kendall, R.J.; Ramkumar, S. Comparison of Hydrophilic PVA/TiO2 and Hydrophobic PVDF/TiO2 Microfiber Webs on the Dye Pollutant Photo-Catalyzation. J. Environ. Chem. Eng. 2020, 8, 103914. [Google Scholar] [CrossRef]
- Prahsarn, C.; Klinsukhon, W.; Roungpaisan, N. Electrospinning of PAN/DMF/H2O Containing TiO2 and Photocatalytic Activity of Their Webs. Mater. Lett. 2011, 65, 2498–2501. [Google Scholar] [CrossRef]
- Montallana, A.D.S.; Lai, B.-Z.; Chu, J.P.; Vasquez, M.R. Enhancement of Photodegradation Efficiency of PVA/TiO2 Nanofiber Composites via Plasma Treatment. Mater. Today Commun. 2020, 24, 101183. [Google Scholar] [CrossRef]
- Ademola Bode-Aluko, C.; Pereao, O.; Kyaw, H.H.; Al-Naamani, L.; Al-Abri, M.Z.; Tay Zar Myint, M.; Rossouw, A.; Fatoba, O.; Petrik, L.; Dobretsov, S. Photocatalytic and Antifouling Properties of Electrospun TiO2 Polyacrylonitrile Composite Nanofibers under Visible Light. Mater. Sci. Eng. B 2021, 264, 114913. [Google Scholar] [CrossRef]
- Shen, H.; Han, M.; Shen, Y.; Shuai, D. Electrospun Nanofibrous Membranes for Controlling Airborne Viruses: Present Status, Standardization of Aerosol Filtration Tests, and Future Development. ACS Environ. Au 2022, 2, 290–309. [Google Scholar] [CrossRef] [PubMed]
- Rengasamy, S.; Shaffer, R.; Williams, B.; Smit, S. A Comparison of Facemask and Respirator Filtration Test Methods. J. Occup. Environ. Hyg. 2017, 14, 92–103. [Google Scholar] [CrossRef]
- Varadharajan Idhaiam, K.S.; Oporto, G.; Barre, M.; Terada, M.; Boyd, J.; Goldsmith, W.; Nurkiewicz, T.; Gupta, R.K.; Sabolsky, E.M. Eco-Friendly Hierarchical Nanoporous Microfiber Respirator Filters Fabricated Using Rotary Jet Spinning Technology (RJS). ACS Appl. Polym. Mater. 2023, 5, 1657–1669. [Google Scholar] [CrossRef]
- Victor, F.S.; Kugarajah, V.; Bangaru, M.; Ranjan, S.; Dharmalingam, S. Electrospun Nanofibers of Polyvinylidene Fluoride Incorporated with Titanium Nanotubes for Purifying Air with Bacterial Contamination. Environ. Sci. Pollut. Res. 2021, 28, 37520–37533. [Google Scholar] [CrossRef] [PubMed]
- Felix Swamidoss, V.; Bangaru, M.; Nalathambi, G.; Sangeetha, D.; Selvam, A.K. Silver-Incorporated Poly Vinylidene Fluoride Nanofibers for Bacterial Filtration. Aerosol Sci. Technol. 2019, 53, 196–206. [Google Scholar] [CrossRef]
- Shen, H.; Zhou, Z.; Wang, H.; Zhang, M.; Han, M.; Durkin, D.P.; Shuai, D.; Shen, Y. Development of Electrospun Nanofibrous Filters for Controlling Coronavirus Aerosols. Environ. Sci. Technol. Lett. 2021, 8, 545–550. [Google Scholar] [CrossRef]
- Saikaew, R.; Intasanta, V. Versatile Nanofibrous Filters against Fine Particulates and Bioaerosols Containing Tuberculosis and Virus: Multifunctions and Scalable Processing. Sep. Purif. Technol. 2021, 275, 119171. [Google Scholar] [CrossRef]
- Xia, T.; Bian, Y.; Zhang, L.; Chen, C. Relationship between Pressure Drop and Face Velocity for Electrospun Nanofiber Filters. Energy Build. 2018, 158, 987–999. [Google Scholar] [CrossRef]
- Li, P.; Wang, C.; Zhang, Y.; Wei, F. Air Filtration in the Free Molecular Flow Regime: A Review of High-Efficiency Particulate Air Filters Based on Carbon Nanotubes. Small 2014, 10, 4543–4561. [Google Scholar] [CrossRef] [PubMed]
- Xu, J.; Xiao, X.; Zhang, W.; Xu, R.; Kim, S.C.; Cui, Y.; Howard, T.T.; Wu, E.; Cui, Y. Air-Filtering Masks for Respiratory Protection from PM2.5 and Pandemic Pathogens. One Earth 2020, 3, 574–589. [Google Scholar] [CrossRef]
- Fouqueau, A.; Pourchez, J.; Leclerc, L.; Peyron, A.; Montigaud, Y.; Verhoeven, P.; Macé, T.; Bescond, A.; Thomas, D.; Charvet, A.; et al. Inter-Laboratory Comparison between Particle and Bacterial Filtration Efficiencies of Medical Face Masks in the COVID-19 Context. Aerosol Air Qual. Res. 2023, 23, 220252. [Google Scholar] [CrossRef]
- Whyte, H.E.; Montigaud, Y.; Audoux, E.; Verhoeven, P.; Prier, A.; Leclerc, L.; Sarry, G.; Laurent, C.; Le Coq, L.; Joubert, A.; et al. Comparison of Bacterial Filtration Efficiency vs. Particle Filtration Efficiency to Assess the Performance of Non-Medical Face Masks. Sci. Rep. 2022, 12, 1188. [Google Scholar] [CrossRef] [PubMed]
- Verleysen, E.; Ledecq, M.; Siciliani, L.; Cheyns, K.; Vleminckx, C.; Blaude, M.-N.; De Vos, S.; Brassinne, F.; Van Steen, F.; Nkenda, R.; et al. Titanium Dioxide Particles Frequently Present in Face Masks Intended for General Use Require Regulatory Control. Sci. Rep. 2022, 12, 2529. [Google Scholar] [CrossRef] [PubMed]
- Kisielinski, K.; Hockertz, S.; Hirsch, O.; Korupp, S.; Klosterhalfen, B.; Schnepf, A.; Dyker, G. Wearing Face Masks as a Potential Source for Inhalation and Oral Uptake of Inanimate Toxins: A Scoping Review. Preprints 2023. [Google Scholar] [CrossRef]
- Azam, F.; Ahmad, F.; Uddin, Z.; Rasheed, A.; Nawab, Y.; Afzal, A.; Ahmad, S.; Zafar, M.S.; Ashraf, M. A Review of the Fabrication Methods, Testing, and Performance of Face Masks. Int. J. Polym. Sci. 2022, 2022, 2161869. [Google Scholar] [CrossRef]
- Brandão, F.; Fernández-Bertólez, N.; Rosário, F.; Bessa, M.J.; Fraga, S.; Pásaro, E.; Teixeira, J.P.; Laffon, B.; Valdiglesias, V.; Costa, C. Genotoxicity of TiO2 Nanoparticles in Four Different Human Cell Lines (A549, HEPG2, A172 and SH-SY5Y). Nanomaterials 2020, 10, 412. [Google Scholar] [CrossRef]
- Valdiglesias, V.; Costa, C.; Sharma, V.; Kiliç, G.; Pásaro, E.; Teixeira, J.P.; Dhawan, A.; Laffon, B. Comparative Study on Effects of Two Different Types of Titanium Dioxide Nanoparticles on Human Neuronal Cells. Food Chem. Toxicol. 2013, 57, 352–361. [Google Scholar] [CrossRef]
- Kansara, K.; Patel, P.; Shah, D.; Shukla, R.K.; Singh, S.; Kumar, A.; Dhawan, A. TiO2 Nanoparticles Induce DNA Double Strand Breaks and Cell Cycle Arrest in Human Alveolar Cells. Environ. Mol. Mutagen. 2015, 56, 204–217. [Google Scholar] [CrossRef] [PubMed]
- Lankoff, A.; Sandberg, W.J.; Wegierek-Ciuk, A.; Lisowska, H.; Refsnes, M.; Sartowska, B.; Schwarze, P.E.; Meczynska-Wielgosz, S.; Wojewodzka, M.; Kruszewski, M. The Effect of Agglomeration State of Silver and Titanium Dioxide Nanoparticles on Cellular Response of HepG2, A549 and THP-1 Cells. Toxicol. Lett. 2012, 208, 197–213. [Google Scholar] [CrossRef] [PubMed]
- Dai, F.; Huang, J.; Liao, W.; Li, D.; Wu, Y.; Huang, J.; Long, Y.; Yuan, M.; Xiang, W.; Tao, F.; et al. Chitosan-TiO2 Microparticles LBL Immobilized Nanofibrous Mats via Electrospraying for Antibacterial Applications. Int. J. Biol. Macromol. 2019, 135, 233–239. [Google Scholar] [CrossRef]
- Deyab, N.M.; Ekram, B.; Badr, K.R.; Abd El-Hady, B.M.; Allam, N.K. Antiviral Electrospun Polyamide Three-Layered Mask Filter Containing Metal Oxide Nanoparticles and Black Seed Oil. ACS Omega 2022, 7, 44438–44447. [Google Scholar] [CrossRef]
- Jao, W.; Yang, M.; Lin, C.; Hsu, C. Fabrication and Characterization of Electrospun Silk Fibroin/TiO2 Nanofibrous Mats for Wound Dressings. Polym. Adv. Techs 2012, 23, 1066–1076. [Google Scholar] [CrossRef]
- Ramasundaram, S.; Son, A.; Seid, M.G.; Shim, S.; Lee, S.H.; Chung, Y.C.; Lee, C.; Lee, J.; Hong, S.W. Photocatalytic Applications of Paper-like Poly(Vinylidene Fluoride)–Titanium Dioxide Hybrids Fabricated Using a Combination of Electrospinning and Electrospraying. J. Hazard. Mater. 2015, 285, 267–276. [Google Scholar] [CrossRef] [PubMed]
- Salazar, H.; Martins, P.M.; Santos, B.; Fernandes, M.M.; Reizabal, A.; Sebastián, V.; Botelho, G.; Tavares, C.J.; Vilas-Vilela, J.L.; Lanceros-Mendez, S. Photocatalytic and Antimicrobial Multifunctional Nanocomposite Membranes for Emerging Pollutants Water Treatment Applications. Chemosphere 2020, 250, 126299. [Google Scholar] [CrossRef]
- Yin, J.; Roso, M.; Boaretti, C.; Lorenzetti, A.; Martucci, A.; Modesti, M. PVDF-TiO2 Core-Shell Fibrous Membranes by Microwave-Hydrothermal Method: Preparation, Characterization, and Photocatalytic Activity. J. Environ. Chem. Eng. 2021, 9, 106250. [Google Scholar] [CrossRef]
- Liang, H.; Wang, N.; Liu, D.; Ge, W.; Song, N.; Wang, F.; Chai, C. Release of Microplastics and Nanoplastics in Water from Disposable Surgical Masks after Disinfection. Mar. Pollut. Bull. 2022, 184, 114184. [Google Scholar] [CrossRef]
- Al-Attabi, R.; She, F.; Zhao, S.; Dumée, L.F.; Schütz, J.A.; Xing, W.; Zhong, Z.; Kong, L. Durable and Comfortable Electrospun Nanofiber Membranes for Face Mask Applications. Sep. Purif. Technol. 2023, 322, 124370. [Google Scholar] [CrossRef]
- Spasova, M.; Manolova, N.; Markova, N.; Rashkov, I. Superhydrophobic PVDF and PVDF-HFP Nanofibrous Mats with Antibacterial and Anti-Biofouling Properties. Appl. Surf. Sci. 2016, 363, 363–371. [Google Scholar] [CrossRef]
- Nasri, N.; Rusli, A.; Teramoto, N.; Jaafar, M.; Ku Ishak, K.M.; Shafiq, M.D.; Abdul Hamid, Z.A. Past and Current Progress in the Development of Antiviral/Antimicrobial Polymer Coating towards COVID-19 Prevention: A Review. Polymers 2021, 13, 4234. [Google Scholar] [CrossRef] [PubMed]
- Ullah, S.; Ullah, A.; Lee, J.; Jeong, Y.; Hashmi, M.; Zhu, C.; Joo, K.I.; Cha, H.J.; Kim, I.S. Reusability Comparison of Melt-Blown vs Nanofiber Face Mask Filters for Use in the Coronavirus Pandemic. ACS Appl. Nano Mater. 2020, 3, 7231–7241. [Google Scholar] [CrossRef] [PubMed]
- Kundu, S.; Karak, N. Polymeric Photocatalytic Membrane: An Emerging Solution for Environmental Remediation. Chem. Eng. J. 2022, 438, 135575. [Google Scholar] [CrossRef]
- Available online: www.inovenso.com (accessed on 1 May 2023).

Disclaimer/Publisher’s Note: The statements, opinions and data contained in all publications are solely those of the individual author(s) and contributor(s) and not of MDPI and/or the editor(s). MDPI and/or the editor(s) disclaim responsibility for any injury to people or property resulting from any ideas, methods, instructions or products referred to in the content. |
© 2023 by the authors. Licensee MDPI, Basel, Switzerland. This article is an open access article distributed under the terms and conditions of the Creative Commons Attribution (CC BY) license (https://creativecommons.org/licenses/by/4.0/).
Share and Cite
Cimini, A.; Borgioni, A.; Passarini, E.; Mancini, C.; Proietti, A.; Buccini, L.; Stornelli, E.; Schifano, E.; Dinarelli, S.; Mura, F.; et al. Upscaling of Electrospinning Technology and the Application of Functionalized PVDF-HFP@TiO2 Electrospun Nanofibers for the Rapid Photocatalytic Deactivation of Bacteria on Advanced Face Masks. Polymers 2023, 15, 4586. https://doi.org/10.3390/polym15234586
Cimini A, Borgioni A, Passarini E, Mancini C, Proietti A, Buccini L, Stornelli E, Schifano E, Dinarelli S, Mura F, et al. Upscaling of Electrospinning Technology and the Application of Functionalized PVDF-HFP@TiO2 Electrospun Nanofibers for the Rapid Photocatalytic Deactivation of Bacteria on Advanced Face Masks. Polymers. 2023; 15(23):4586. https://doi.org/10.3390/polym15234586
Chicago/Turabian StyleCimini, Adriano, Alessia Borgioni, Elena Passarini, Chiara Mancini, Anacleto Proietti, Luca Buccini, Eleonora Stornelli, Emily Schifano, Simone Dinarelli, Francesco Mura, and et al. 2023. "Upscaling of Electrospinning Technology and the Application of Functionalized PVDF-HFP@TiO2 Electrospun Nanofibers for the Rapid Photocatalytic Deactivation of Bacteria on Advanced Face Masks" Polymers 15, no. 23: 4586. https://doi.org/10.3390/polym15234586
APA StyleCimini, A., Borgioni, A., Passarini, E., Mancini, C., Proietti, A., Buccini, L., Stornelli, E., Schifano, E., Dinarelli, S., Mura, F., Sergi, C., Bavasso, I., Cortese, B., Passeri, D., Imperi, E., Rinaldi, T., Picano, A., & Rossi, M. (2023). Upscaling of Electrospinning Technology and the Application of Functionalized PVDF-HFP@TiO2 Electrospun Nanofibers for the Rapid Photocatalytic Deactivation of Bacteria on Advanced Face Masks. Polymers, 15(23), 4586. https://doi.org/10.3390/polym15234586

